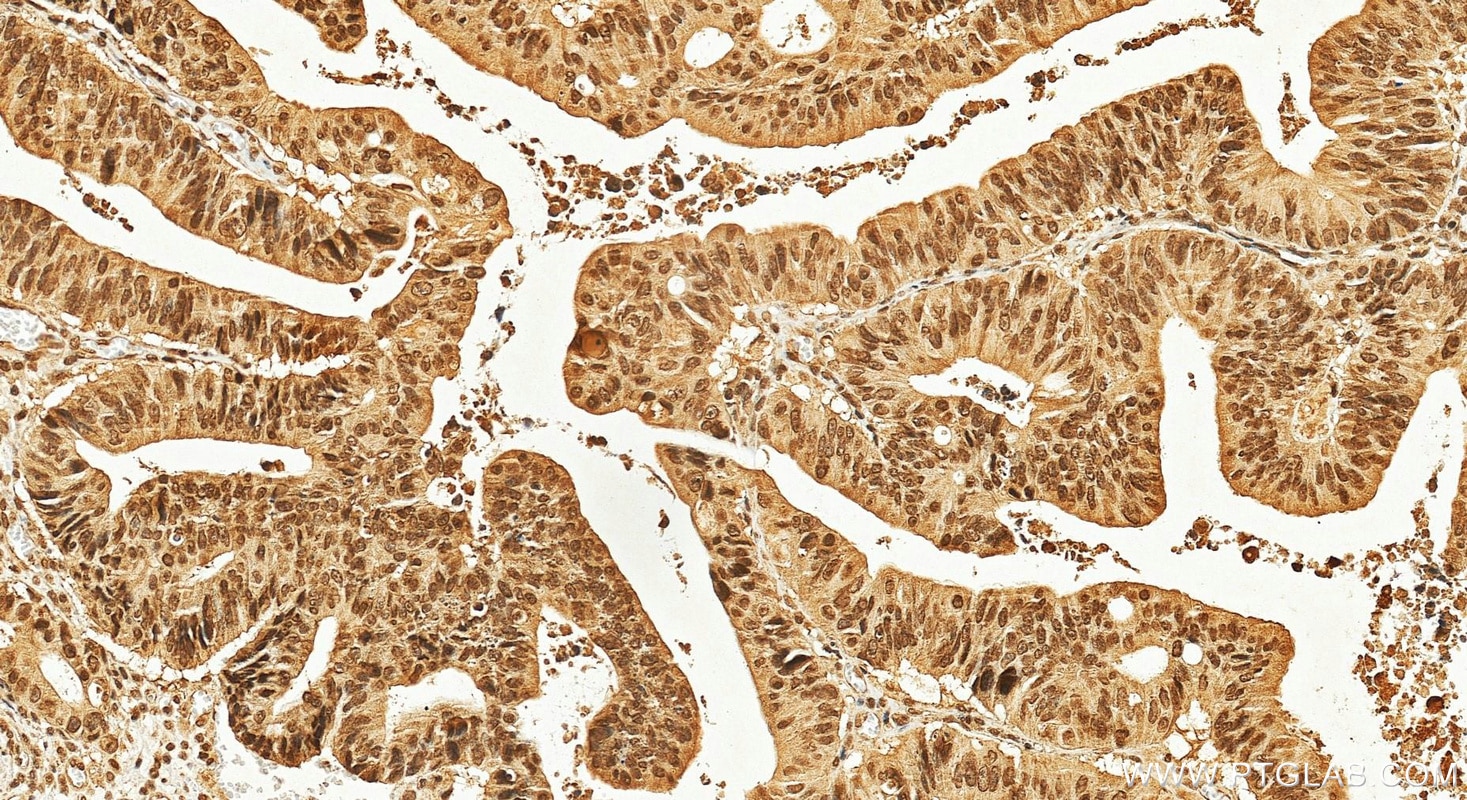
Immunohistochemistry (IHC) staining of human colon cancer tissue using CRM1 Monoclonal antibody (66763-1-Ig)

Published Applications
| IHC | See 1 publications below |
Product Information
66763-1-PBS targets CRM1 in WB, IHC, IF/ICC, Indirect ELISA applications and shows reactivity with human, mouse, rat samples.
| Tested Reactivity | human, mouse, rat |
| Cited Reactivity | human |
| Host / Isotype | Mouse / IgG1 |
| Class | Monoclonal |
| Type | Antibody |
| Immunogen |
CatNo: Ag27337 Product name: Recombinant human XPO1 protein Source: e coli.-derived, PET28a Tag: 6*His Domain: 301-540 aa of BC032847 Sequence: NTNIRLAYSNGKDDEQNFIQNLSLFLCTFLKEHDQLIEKRLNLRETLMEALHYMLLVSEVEETEIFKICLEYWNHLAAELYRESPFSTSASPLLSGSQHFDVPPRRQLYLPMLFKVRLLMVSRMAKPEEVLVVENDQGEVVREFMKDTDSINLYKNMRETLVYLTHLDYVDTERIMTEKLHNQVNGTEWSWKNLNTLCWAIGSISGAMHEEDEKRFLVTVIKDLLGLCEQKRGKDNKAII Predict reactive species |
| Full Name | exportin 1 (CRM1 homolog, yeast) |
| Calculated Molecular Weight | 1071 aa, 123 kDa |
| Observed Molecular Weight | 100-110 kDa |
| GenBank Accession Number | BC032847 |
| Gene Symbol | CRM1 |
| Gene ID (NCBI) | 7514 |
| RRID | AB_2882109 |
| Conjugate | Unconjugated |
| Form | Liquid |
| Purification Method | Protein G purification |
| UNIPROT ID | O14980 |
| Storage Buffer | PBS only, pH 7.3. |
| Storage Conditions | Store at -80°C. |
Background Information
CRM1 (chromosome region maintenance 1, also known as exportin-1 or XPO1), a member of the karyopherin β family of transport receptors, is an important nuclear export receptor recognizing proteins bearing a leucine-rich nuclear export signal (PMID: 9323133). CRM1 is the major receptor for the export of proteins out of the nucleus and is also required for transport of many RNAs (PMID: 17317185). In addition to nuclear export, CRM1 also plays a role in centrosome duplication and spindle assembly (PMID: 22773955). Elevated CRM1 expression has been reported in several cancers, which implicates CRM1 as a potential anti-cancer drug target (PMID: 22677130; 21683812 ).